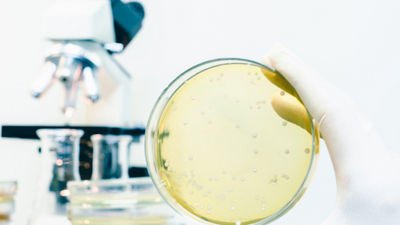
细菌和微生物

Aseptic solutions for safe food
失学技术至少使食物安全易味半年-没有冷冻或防腐剂允许食物保留更多颜色、纹理、口味和营养。 我们无菌打包提供各种打包形状、消费者方便度和经济化能源和打包材料
进取过程确保食品和打包材料无有害细菌生产链中所有内容都非商业消毒包括食品和打包材料、所有机器和打包环境华府
UHT技术软化解决方案
超热处理-UHT-最大限度地销毁奶制品和奶制品替代物中的微生物灵活高成本效益技术可实现创新产品组合、减少碳足迹并加之零散打包、长产品架存存存期找出最先进UHT解决方案和专门知识如何帮助你恢复运算能力
失序打包
稀疏包填充UHT处理食品前已被消毒,结果产物架稳定达6个月以上
稀疏打包法平坦整理材料 通过加热过氧化氢浴过氧化氢浓度30%在70摄氏度加热六秒过氧化氢再用压滚机或热空气从包装材料中消除
处理和密封食物环境也必须无潜在污染细菌表示填充和封存机制在包装前和生产过程期间必须消毒可使用热空气和蒸汽或热处理与过氧化氢化学消毒相结合实现这一点。
稀疏打包法平坦整理材料 通过加热过氧化氢浴过氧化氢浓度30%在70摄氏度加热六秒过氧化氢再用压滚机或热空气从包装材料中消除
处理和密封食物环境也必须无潜在污染细菌表示填充和封存机制在包装前和生产过程期间必须消毒可使用热空气和蒸汽或热处理与过氧化氢化学消毒相结合实现这一点。
食品消毒
商业消毒食品需加热到规定时间段定温具体温度和时间取决于所涉食物低酸液食品如牛奶比高酸产品如果汁更容易接触微生物和病原体
UHT或超高温处理在打包前优化热交换器中进行这一过程尽量减少热渗透问题并允许极短取暖和冷却时间,同时尽量减少产品口味和营养特性的意外变化
回想-销毁微生物
甚至在Louis Pasteur上百年前证明微生物引起发酵和疾病前,Nicolas Appert(巴黎美食家)首先成功地将某些食品保存在玻璃瓶中,这些瓶子曾在不同时间里存放在开水中。发生于1800年代前十年和1839年锡层钢容器广泛使用开始高热处理和罐头生产,以此保存食物
持续热处理和无菌打包组合以高成本效益方式生产高质量食品
热处理架稳食品
反压缩是一个容器内消毒过程,包件和食物内装物长时间接触高压和潮湿环境中高温时间和温度接触取决于哪些食品被消毒,同型食品不同生产者之间也会有差异。
批量处理对任何包型都难处理,传统上主要使用金属罐和玻璃罐带Tetra Recart®现在就有可能有一个基于盒式包管理硬反压缩过程开发TetraRecart时的主要挑战是如何寻找能够承受回文内条件并管理最长达2年存积的打包材料结构包中的每一层都有自身特定目的并并加在一起将食物安全置入包中